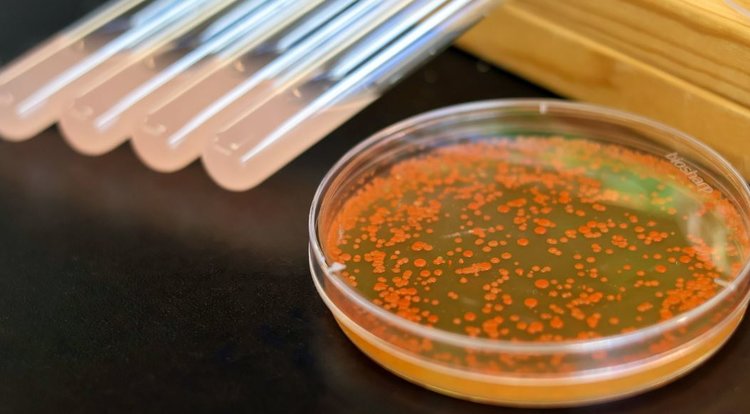

Микробное масло вместо растительного: ученые научились «доить» дрожжи ради полезных омега-жиров
Мир ищет замену традиционным растительным и рыбным маслам — их производство дорого обходится экологии. Решение нашлось в микромире: дрожжи Yarrowia lipolytica оказались настоящими «профессиональными накопителями» жира. Они способны запасать липиды в объеме более 20% от собственного веса!